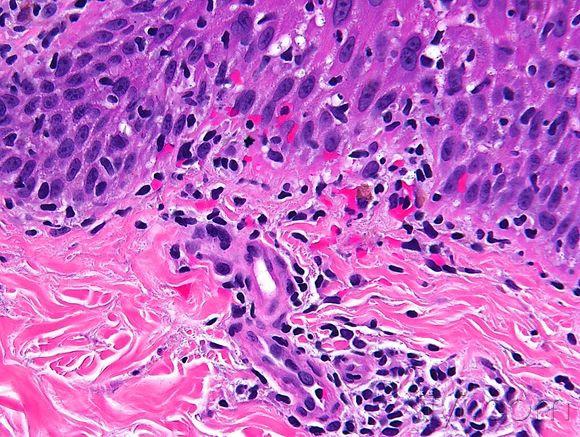
皮肤临床病理06线状苔藓

线状苔癣

线状苔藓一例
图片尺寸1024x768
公布答案:线状苔藓 - 皮肤及性传播疾病讨论版 - 爱爱医医学论坛
图片尺寸1024x768
照片圈内白色线条状是扁平苔藓和纤维化吗?担心
图片尺寸576x1024
看图识病---------线状苔藓后色素脱失症
图片尺寸1024x768
皮肤病初次诊断 线状扁平苔藓.#求助广大网友 #皮肤#线状扁 - 抖音
图片尺寸1440x1920
左胳膊上臂有一片白斑,这是什么皮肤病,怎么治.
图片尺寸2448x3264
线状苔藓
图片尺寸680x727
看图识病右臂线状白斑
图片尺寸1024x768
问:手上不知道什么时候长了一大片……这是什么?湿疹么?擦什么药会好?
图片尺寸375x500
病例讨论看图识病
图片尺寸700x525
线状苔藓终于好转了
图片尺寸640x640
线状苔藓 长成一条线的就是线状苔癣?
图片尺寸640x426
与blaschko线一致的线状苔藓一例
图片尺寸588x740
jaad:干扰素诱发线状苔藓 1 例
图片尺寸640x459
皮肤临床病理06线状苔藓
图片尺寸580x437
看图诊断---答案已给出---汗孔角化症!
图片尺寸1024x768
癣- 好大夫在线
图片尺寸600x688
皮肤临床病理06线状苔藓
图片尺寸580x437
我长了2年的线状苔藓总算好了
图片尺寸1080x1439
磨擦性苔癣样疹
图片尺寸1024x768